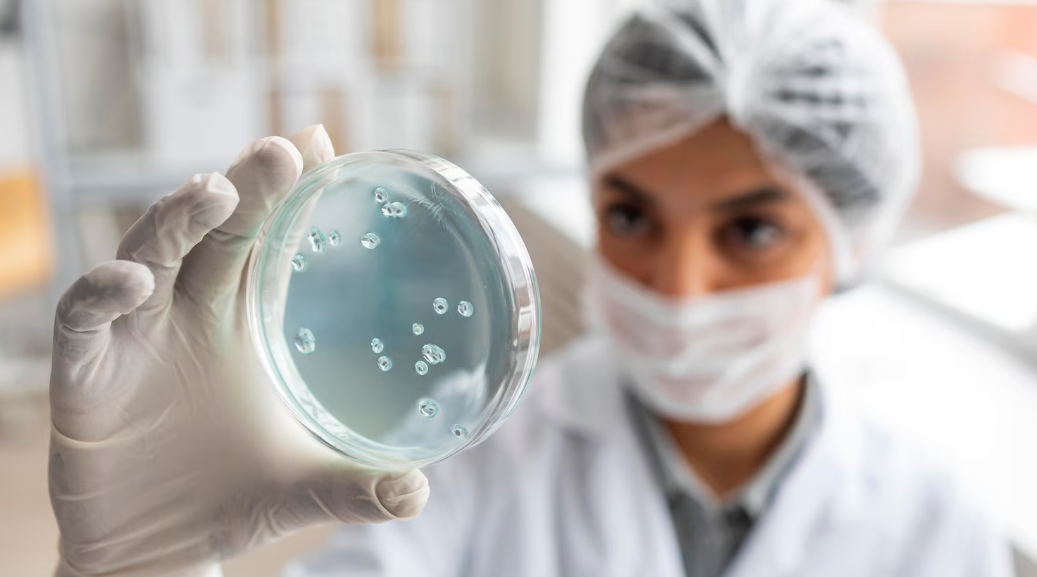
Profissional realiza testes em equipamentos laboratoriais voltados à avaliação de organismos geneticamente modificados

A agricultura sempre foi um pilar fundamental para a sobrevivência e o desenvolvimento humano. Desde os primeiros cultivos, há milênios, até os dias atuais, a busca por maior produtividade, resistência a pragas e adaptação às mudanças climáticas impulsionou a inovação no campo.
Hoje, a biotecnologia agrícola surge como uma revolução silenciosa, transformando a maneira como produzimos alimentos por meio de técnicas como a modificação genética de plantas.
Neste artigo, você descobrirá como os transgênicos impactam desde o pequeno produtor até o consumidor final, quais são os prós e contras dessa tecnologia.
O que é biotecnologia agrícola?
O que são alimentos geneticamente modificados?
Em que esses alimentos podem ser usados?
Vantagens e desvantagens de alimentos geneticamente modificados
O que é biotecnologia agrícola?
 A biotecnologia agrícola utiliza técnicas científicas para modificar organismos, como plantas e micróbios, com o objetivo de melhorar características como produtividade, resistência a pragas e valor nutricional.
A biotecnologia agrícola utiliza técnicas científicas para modificar organismos, como plantas e micróbios, com o objetivo de melhorar características como produtividade, resistência a pragas e valor nutricional.
Isso inclui a engenharia genética, que consiste na inserção de genes específicos, como o gene de bactérias no milho, para conferir resistência a determinadas pragas. Também envolve a edição genética, utilizando a tecnologia CRISPR para "corrigir" o DNA das plantas sem a necessidade de inserir genes externos. Outra técnica é o cultivo de tecidos, que permite a clonagem de mudas de café resistentes à seca.
“Há registros da utilização da biotecnologia desde os tempos antigos.”
Nutrição de Safras — link
Em 2023, o Brasil consolidou-se como o 2º maior produtor de transgênicos do mundo, com 95% da soja e 88% do milho plantados sendo geneticamente modificados.
O que são alimentos geneticamente modificados?
Os alimentos geneticamente modificados são aqueles que tiveram seu DNA alterado em laboratório para adquirir características específicas.
Diferentemente do melhoramento convencional, que envolve o cruzamento de plantas, a modificação genética permite a transferência de genes até de espécies não relacionadas.
No Brasil, alguns exemplos notáveis incluem a soja intacta, que é resistente a herbicidas e lagartas; o feijão imune ao vírus do mosaico dourado, e a cana-de-açúcar Bt, que é tolerante à broca-da-cana.
Em que esses alimentos podem ser usados?
O s produtos derivados de organismos geneticamente modificados têm diversas aplicações em diferentes setores. No consumo humano, por exemplo, o óleo de soja transgênica e o amido de milho são amplamente utilizados na alimentação.
s produtos derivados de organismos geneticamente modificados têm diversas aplicações em diferentes setores. No consumo humano, por exemplo, o óleo de soja transgênica e o amido de milho são amplamente utilizados na alimentação.
Esses produtos são modificados geneticamente para melhorar características como resistência a pragas e produtividade, resultando em alimentos mais acessíveis e com potencial de maior qualidade nutricional.
No setor de ração animal, cerca de 70% da soja transgênica brasileira é destinada à alimentação de frangos e suínos. A modificação genética dessas plantas permite um cultivo mais eficiente e produtivo, proporcionando uma fonte de alimento rica em proteínas para a indústria de criação de animais.
Em relação aos biocombustíveis, a cana-de-açúcar modificada geneticamente tem demonstrado um aumento na produção de etanol. Essa inovação contribui para a produção de biocombustíveis de forma mais sustentável e eficiente, ajudando a reduzir a dependência de combustíveis fósseis e as emissões de gases de efeito estufa.
Na indústria farmacêutica, o arroz dourado, também conhecido como Golden Rice, é um exemplo significativo. Este arroz foi enriquecido com vitamina A, visando combater a deficiência dessa vitamina em regiões onde o arroz é um alimento básico.
Nesse sentido, a deficiência de vitamina A pode levar a problemas de saúde graves, incluindo a cegueira. O arroz dourado oferece uma solução acessível e prática para melhorar a saúde e a nutrição de milhões de pessoas ao redor do mundo.
Esses exemplos ilustram como a biotecnologia agrícola e a modificação genética estão sendo utilizadas para promover melhorias significativas na alimentação, na agricultura, na produção de energia e na saúde pública.
“A biotecnologia tem contribuído para melhorar a qualidade de plantas e aumentar a produtividade agrícola, de forma sustentável e focada na conservação ambiental.”
Fonte: Como a biotecnologia pode ser aplicada à agricultura?
Vantagens
- Redução de agrotóxicos: as culturas Bt, que são geneticamente modificadas para produzir toxinas que combatem pragas específicas, permitem uma redução significativa na aplicação de inseticidas. Isso não só reduz os custos para os agricultores, mas também minimiza os impactos ambientais negativos associados ao uso excessivo de agrotóxicos;
- Aumento da produtividade: a soja geneticamente modificada para ser tolerante à seca apresenta um aumento de produtividade em regiões semiáridas. Isso é fundamental para garantir a viabilidade agrícola em áreas com disponibilidade limitada de água, ajudando a manter a produção e a renda dos agricultores em tempos de condições climáticas adversas;
- Nutrição aprimorada: o arroz biofortificado com ferro é um exemplo de como a modificação genética pode melhorar o valor nutricional dos alimentos. Esse tipo de arroz é especialmente importante em regiões onde a anemia por deficiência de ferro é prevalente, fornecendo uma fonte adicional de ferro na dieta das populações afetadas.
Desvantagens:
- Riscos à biodiversidade: a polinização cruzada entre plantas geneticamente modificadas e plantas selvagens ou convencionais pode levar à criação de "superinvasoras". Estas são plantas que têm características indesejáveis e podem dominar ecossistemas naturais, prejudicando a biodiversidade;
- Dependência de sementes: uma grande desvantagem dos OGMs é a concentração do mercado de sementes. Isso cria uma dependência dos agricultores em relação a essas empresas para adquirir sementes, o que pode levar a preços mais altos e menor diversidade de sementes disponíveis;
- Resistência a herbicidas: o uso extensivo de herbicidas em culturas transgênicas pode resultar na seleção de ervas daninhas resistentes. Isso aumenta a dificuldade e o custo de controle de ervas daninhas, forçando os agricultores a utilizarem herbicidas mais fortes ou técnicas de manejo alternativas.
Vantagens e desvantagens dos alimentos geneticamente modificados |
||
| Dimensão | Exemplos de vantagens (do texto) | Exemplos de desvantagens (do texto) |
|---|---|---|
| Uso de insumos | Redução de agrotóxicos em culturas Bt que produzem toxinas contra pragas específicas. | Seleção de ervas daninhas resistentes devido ao uso extensivo de herbicidas. |
| Produtividade | Aumento da produtividade de soja tolerante à seca em regiões semiáridas. | Dependência de sementes de poucas empresas e possível aumento de custos. |
| Nutrição e ambiente | Arroz biofortificado com ferro e outros nutrientes para populações vulneráveis. | Riscos à biodiversidade com possível formação de “superinvasoras”. |
“A partir daí, a biotecnologia na agricultura emergiu na vanguarda da ciência, prometendo contribuir na produção de alimentos.”
Fonte: Biotecnologia na agricultura: como funciona e quais os benefícios
Como é feito o controle de qualidade?
No Brasil, a Comissão Técnica Nacional de Biossegurança (CTNBio) estabelece uma série de exigências rigorosas para a aprovação de organismos geneticamente modificados (OGMs).
No Brasil, a Comissão Técnica Nacional de Biossegurança (CTNBio) estabelece uma série de exigências rigorosas para a aprovação de organismos geneticamente modificados (OGMs).
Dessa forma, é realizada uma análise de risco ambiental, que avalia o impacto dos OGMs sobre abelhas, solo e outros componentes do ecossistema. Esse passo é indispensável para garantir que a introdução de OGMs não cause desequilíbrios ecológicos ou prejudique espécies benéficas.
Em seguida, são conduzidos testes toxicológicos para verificar a alergenicidade e os efeitos dos OGMs em animais. Esses testes são essenciais para assegurar que eles não apresentem riscos à saúde humana ou animal, evitando possíveis reações alérgicas e outros efeitos adversos.
Além disso, há uma exigência de rotulagem para produtos que contenham mais de 1% de transgênicos. Isso significa que os consumidores devem ser informados sobre a presença de OGMs nos produtos que compram, garantindo a transparência e permitindo escolhas informadas.
As mitigações de risco quanto à segurança alimentar envolvem estudos de longo prazo e monitoramento pós-comercialização. Uma meta-análise de 1.783 pesquisas, realizada pela National Academy of Sciences em 2016, concluiu que os transgênicos são seguros.
Conclusão
A biotecnologia agrícola é uma ferramenta poderosa, mas não isenta de dilemas. Enquanto aumenta a produtividade e reduz custos para agricultores, exige regulamentação rigorosa para evitar danos ambientais. Se você tem interesse no tema, especializar-se em biotecnologia agrícola abre portas em grandes empresas do setor.
FAQ
-
Alimentos transgênicos são seguros para consumo humano?
No Brasil, os OGMs aprovados passam pela avaliação da CTNBio, com estudos de risco ambiental, testes toxicológicos e monitoramento pós-comercialização, o que indica um nível de segurança semelhante ao de alimentos convencionais.
-
Quais são as principais vantagens dos alimentos geneticamente modificados?
Entre as vantagens estão a redução do uso de agrotóxicos, o aumento da produtividade em regiões com seca e a possibilidade de desenvolver alimentos biofortificados, como arroz enriquecido com ferro ou vitamina A.
-
Quais desafios e riscos acompanham o uso de transgênicos?
Os principais desafios relacionam-se a possíveis impactos na biodiversidade, à dependência de sementes fornecidas por poucas empresas e ao surgimento de ervas daninhas resistentes, exigindo regulação e manejo responsáveis.
Bayer. Benefícios da biotecnologia na agricultura.
CropLife Brasil. Como a biotecnologia pode ser aplicada à agricultura?






